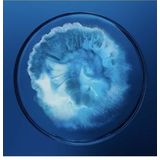
Biotherm - Force - Lichaamsbehandeling - 100ml - Revitaliserende Formule

Auto'sBaby & peuterBoekenCadeaus & gadgetsComputersDierenbenodigdhedenDrogisterijElektronicaErotiekEten & drinkenFietsenFilms & SeriesGamesHorlogesHuishoudelijkKantoorKledingKlussenMeubelsMode accessoiresMultimedia-accessoiresMuziekinstrumentenParfumerieSanitairSchoenenSieradenSoftwareSpeelgoedSport & OutdoorTuinartikelenWoonaccessoires
Als laatst door jou gezocht
0Cookies op beslist.nl
Beslist.nl gebruikt functionele en analytische cookies voor website optimalisatie en statistieken. Verder gebruiken wij en eventuele partners cookies om persoonlijke aanbevelingen en advertenties te tonen binnen en buiten onze website. Als je op “Accepteren” klikt, dan geef je beslist.nl toestemming om cookies gepersonaliseerde advertenties te plaatsen. Kies je voor “Weigeren”, dan plaatsen we alleen functionele en analytische cookies. Lees hier meer over in onze cookieverklaring en ons privacybeleid. In de cookieverklaring lees je ook hoe je de cookies kunt intrekken.
Biotherm - Force - Lichaamsbehandeling - 100ml - Revitaliserende Formule

Populair

+4
Basler-beauty.nl
€81,17
€1,99 verzending | 2-4 dagen
Laagste totaalprijs
Gratis retour
Bekijk
Bekijk
Flaconi.nl
€86,72
Gratis verzending | 2-3 dagen
912.80/1000 ml
Gratis retour
Achteraf betalen
Bekijk
Bekijk
Deloox.nl
€89,49
€124,50
Gratis verzending | 5 dagen
Hoge korting
Bekijk
Bekijk
Anderen bekeken ook
Prijsontwikkeling
Is de huidige prijs een goede deal? De grafiek toont de laagste prijs per dag, exclusief verzendkosten.
Laagste prijsSpecificaties
MerkBloem
DoelgroepMannen, Volwassenen
Inhoud100 ml
Beschrijving
Ontdek de Biotherm Homme Force Supreme Gel in jumboformaat.
De Force Supreme gezichtsgel van Biotherm Homme is een effectieve anti-verouderingsbehandeling voor mannen om de zichtbare tekenen van huidveroudering te verminderen. De gezichtsgel, verrijkt met Biotech Plankton, blauwalgenextract en Pro-Xylane, bestrijdt rimpels, een doffe teint en verlies van stevigheid. Bij elk gebruik wordt de huid intensief gehydrateerd en de elasticiteit verbeterd - voor een jeugdigere en stralende teint. De lichte geltextuur wordt onmiddellijk opgenomen en geeft de huid een aangenaam gehydrateerd gevoel zonder vet of plakkerig aan te voelen. Nu in duurzamere verpakking en zonder cellofaanverpakking.
Ultraverfrissende gelNiet vet en niet glanzend24 uur hydraterend
Toepassing: Breng 's ochtends en/of 's avonds aan. Vermijd de oogcontour.
Waarschuwing: Bij contact met de ogen onmiddellijk grondig uitspoelen.
Trending
Clinique GezichtscrèmesOlay GezichtscrèmesClarins GezichtscrèmesBiotherm gezichtsverzorgingDagcrème van Estee LauderLouis Widmer GezichtscrèmesGezichtscrèmes van ZarqaGezichtscrèmes van Estee LauderEstee Lauder SerumLa Roche-Posay SerumGezichtscrèmes van Dr. HauschkaMixa MoisturizerGezichtscrèmes van CeraVeDagcrème van KruidvatLancome GezichtscrèmesNiacinamide GezichtscrèmesGezichtscrèmes van KruidvatNivea Mannen GezichtscrèmesDagcrème van WeledaClarins SerumShiseido GezichtscrèmesGezichtscrèmes Zeer droge huidDagcrème van ClarinsEucerin Gezichtscrèmes voor een Stralende HuidGezichts Moisturizer voor HydratatieDagcrème voor het gezichtWeleda Verstevigende Dagcrème Oudere HuidParfumvrije Dagcrème Gevoelige huidGezichtscrèmes van FILORGANachtcrème van EucerinL'Oréal DagcrèmeJacob Hooy Vitamine E GezichtscrèmesLancome DagcrèmeClinique Dagcrème voor een stralende huidGezichts dagcrème met SPFGezichtscrèmes voor kinderenEucerin Dagcrème voor de gevoelige huidThe Ordinary SerumGezichtscrèmes van CaudalieWeleda Dagcrème VerstevigendGezichtscrèmes van BiodermalCeraVe Volwassenen moisturizerLa Mer GezichtscrèmesNivea Gezichtscrèmes voor DamesLa Roche-Posay DagcrèmeVichy NachtcremeL'Oréal Collageen DagcrèmeVichy gezichtscrèmes 50 mlL'Oréal Collageen GezichtscrèmesDagcrème van VichyHyaluronzuur GezichtscrèmesVichy Dagcrème Droge huidAnti-aging Serum voor Oudere Huid Dames 1000 mlBiotherm Mannen GezichtscrèmesNivea Dagcrème Oudere huid Anti-agingNivea Dagcrème met SPFBiotherm NachtcrèmeGezichtscrèmes van Drs. LeenartsL'Oréal GezichtscrèmesGarnier NachtcrèmeNivea Gezichtscrèmes met SPFDagcrème van CaudalieDagcrème van EtosShiseido Gezichtscrèmes 75 mlGezichtscrèmes met SPFShiseido DagcrèmeBiodermal Crème voor overdag en 's nachtsDagcrème van DiadermineGezichtscrèmes van WeledaWeleda Collageen Gezichtscrème Anti-AgingGezichtscrèmes van Sans SoucisDagcrème van NiveaEucerin Dag- en nachtcrèmeOlay DagcrèmeEtos GezichtscrèmesLa Roche-Posay - Anti-aging - Oudere huid - Dames - 15 ml GezichtscrèmesLouis Widmer NachtcrèmeGezichts Dag en NachtcrèmeBabor DagcrèmeGezichtscrèmes van LancasterLa Roche-Posay Crème voor dag en nachtNivea gezichtscrèmes HydraterendBergman Dag en NachtcrèmeRituals Gezichtscrèmes voor MannenDagcrème - Beschermend - Zeer droge huid - Hyaluronzuur - 50 ml GezichtscrèmesLancome Gezichtscrèmes voor DamesEucerin Hyaluron-Filler NachtcrèmeLa Prairie GezichtscrèmesLa Roche-Posay Dagcrème Zeer droge huidClarins gezichtscrèmes 50 mlDagcrème van Dr. HauschkaClarins Nachtcrème voor een stralende huidGezichtscrème voor de oudere huid - 50 mlHyaluronzuur Serum Droge huidCharlotte Tilbury GezichtscrèmesGezichtscrèmes van RitualsLa Roche-Posay Mannen GezichtscrèmesFILORGA DagcrèmeEstee Lauder Advanced Night Repair GezichtscrèmesLouis Widmer Crème voor dag en nacht
Algemeen
Bestellen op beslist.nl
Bestellen & leveringRetournerenKlachtenVoorwaarden winkelwagen
Vergelijken • kiezen • kopen
Bij beslist.nl vergelijk je snel prijzen en producten van duizenden webshops. Als de grootste vergelijkingssite van Nederland helpen wij consumenten al meer dan 20 jaar met het vinden van de beste aanbiedingen en producten. Met een assortiment van meer dan 80 miljoen producten maken we jouw online winkelervaring zo makkelijk mogelijk.
Zoek je een product dat morgen in huis is? Wil je de laagste prijs of snel prijzen vergelijken van verschillende aanbieders? Online shoppen begint bij beslist.nl!
De prijzen van de getoonde producten op beslist.nl zijn incl. BTW en exclusief eventueel bijkomende verzendkosten.
